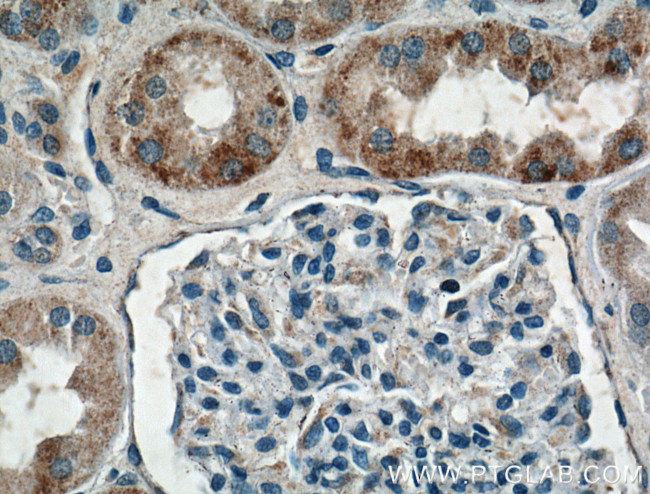
HTR2B Antibody in Immunohistochemistry (Paraffin) (IHC (P))

Search
Proteintech
HTR2B Polyclonal Antibody
{{$productOrderCtrl.translations['antibody.pdp.commerceCard.promotion.promotions']}}
{{$productOrderCtrl.translations['antibody.pdp.commerceCard.promotion.viewpromo']}}
{{$productOrderCtrl.translations['antibody.pdp.commerceCard.promotion.promocode']}}: {{promo.promoCode}} {{promo.promoTitle}} {{promo.promoDescription}}. {{$productOrderCtrl.translations['antibody.pdp.commerceCard.promotion.learnmore']}}
产品信息
26408-1-AP
种属反应
宿主/亚型
分类
类型
抗原
偶联物
形式
浓度
规格
纯化类型
保存液
内含物
保存条件
运输条件
产品详细信息
Immunogen sequence: MALSYRVSE LQSTIPEHIL QSTFVHVISS NWSGLQTESI PEEMKQIVEE QGNKLHW (1-56 aa encoded by B C063123)
靶标信息
HTR2B is a g-protein coupled receptor for 5-hydroxytryptamine (serotonin). It functions as a receptor for various ergot alkaloid derivatives and psychoactive substances. Ligand binding causes a conformation change that triggers signaling via guanine nucleotide-binding proteins (G proteins) and modulates the activity of down-stream effectors. HTR2B also plays a role in perception of pain, regulation of behavior. It is required to normal proliferation of embryonic cardiac myocytes and normal heart development.
仅用于科研。不用于诊断过程。未经明确授权不得转售。
生物信息学
蛋白别名: 5-HT 2B receptor; 5-HT-2B; 5-HT-2F; 5-HT2b receptor; 5-hydroxytryptamine (serotonin) receptor 2B, G protein-coupled; 5-hydroxytryptamine 2B receptor; 5-hydroxytryptamine receptor 2B; 5HT2B Receptor; NP75 protein; serotonin; Serotonin receptor 2B; unnamed protein product
基因别名: 5-HT(2B); 5-HT-2B; 5-HT2B; AJ012488; AV377389; HTR2B
UniProt ID: (Human) P41595, (Mouse) Q02152
Entrez Gene ID: (Human) 3357, (Mouse) 15559